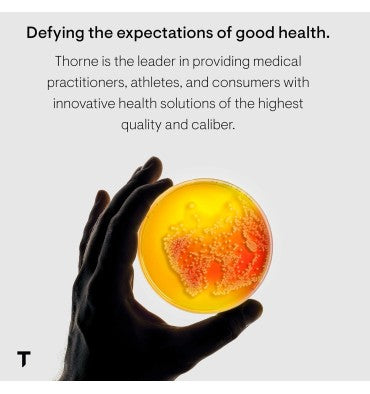
Citramato de Magnesio. 90 caps

- Sku:
Citramato de Magnesio. 90 caps
$ 990.00
Impuesto incluido.
Los gastos de envío se calculan en la pantalla de pago.
Inventario disponible!
Producto Premium
Envío Aéreo y Terrestre
Thorne Research - Citramato de Magnesio, Magnesio con Citrato-Malato para promover la producción de energía, la función cardíaca y pulmonar y el metabolismo del azúcar y los carbohidratos. 90 cápsulas
- Para una deficiencia común: El magnesio es a menudo deficiente en la dieta americana.
- Múltiples beneficios: El suplemento de magnesio beneficia la producción de energía, la función del corazón y la función pulmonar y promueve el metabolismo del azúcar y otros carbohidratos.
- Debilidad muscular/fatiga: El magnesio y el malato (ácido málico) proporcionan apoyo a las personas con debilidad muscular y fatiga.
- Riñón: El magnesio y el citrato apoyan la función renal al disminuir el oxalato de calcio y el fosfato en la orina.
- Libre de: Cada producto Thorne está elaborado con los ingredientes más puros posibles. Sin gluten ni ningún otro alérgeno importante (huevos, frutos secos, maní). Este producto no contiene soya, lácteos, levadura, mariscos o pescado.
Have a question?







Citramato de Magnesio. 90 caps
$ 990.00